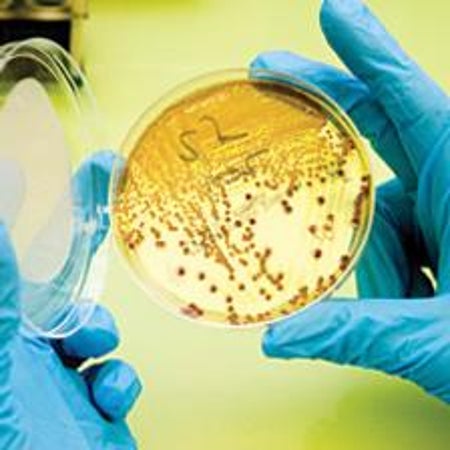
大眾科學 Logo

墨西哥灣漏油事件將持續多久?
這不僅是阻止洩漏的問題,也是石油最終去向的問題
戴維·比埃洛是大眾科學的特約編輯。

墨西哥灣漏油事件將持續多久?
這不僅是阻止洩漏的問題,也是石油最終去向的問題

智慧電網幕後:智慧電網會是什麼樣子? [幻燈片]
從螺母螺栓、變壓器和電纜的角度來看待變得更智慧的電網

效率的提升:利用更最佳化的渦輪機發電
改進渦輪機是現代電網核心的關鍵,一切都為了應對高溫

智慧電網的啟動陣痛
智慧電網將節省能源和資金,但實施可能代價高昂

變性除草劑
廣泛使用的除草劑莠去津擾亂了青蛙的性發育

IPCC錯誤促使對氣候科學資料進行審查

石油洩漏惡化,海上鑽井計劃岌岌可危?

聯邦政府批准科德角海上風力發電場

構建更好的生物燃料:一種新的碳中和方法將碳水化合物轉化為碳氫化合物
利用熱量、壓力和催化劑將植物糖轉化為汽油

後處理是消除炸彈和核廢料中裂變材料的答案嗎?
在核反應堆中燃燒鈽和其他裂變材料可能是處理危險材料的好方法

是什麼導致了北大西洋浮游植物的爆發?
瞭解是什麼導致北大西洋每年浮游植物的爆發可能對於理解這些微小的植物將如何應對氣候變化至關重要

砍伐與擴張:美國東部森林恢復衰退
自 20 世紀 70 年代以來,原本已經恢復的林地再次開始萎縮

避免曬傷:屋頂太陽能電池板安全測試
新的設施使用從槍支到極端溫度的一切手段來測試光伏和其他清潔能源技術的安全性

如何保護地球上生命的廣度
新的工具試圖捕捉當前正在進行的第六次物種大滅絕,同時也強調了阻止它的方法

不再有新的核武器:奧巴馬的核姿態指向謹慎

什麼是地球工程?為什麼它被認為是氣候變化的解決方案?
一些科學家呼籲更多地研究技術干預措施,以阻止災難性的全球變暖。為什麼?

沿東海岸的離岸渦輪機陣列可以提供穩定的風力

爆炸性矽烷氣體給太陽能產業蒙上陰影
矽烷氣體已經造成電池製造廠的工人死傷。光伏產業可以沒有它嗎?

美國應對氣候變化的行動始於汽車和卡車
首個旨在減少溫室氣體排放的國家法規旨在降低車輛的燃料消耗

更高的水位線
冰河時代的海平面上升引發了關於冰川融化的問題
細菌生物燃料
大腸桿菌轉變為纖維素吞噬型生物柴油精煉廠

BPA 是一種“令人擔憂的化學物質”——EPA 正式宣佈

搞什麼鬼?來自地下頁岩的天然氣有望實現美國能源獨立——但環境代價幾何? [幻燈片]
從頁岩礦床中裂解出的天然氣可能意味著美國擁有一個世紀的穩定供應——但環境和人類健康的代價是什麼?

有什麼辦法可以阻止地鐵爆炸案嗎?